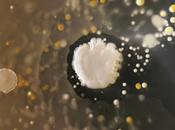
Bioarte creado bacteria encuentra smartphones

Ciudades — Surrey
Ciudades — Surrey
-
Notas de producción oficiales de Thor: El Mundo Oscuro
Marvel ha publicado las notas de producción oficiales de Thor: El Mundo Oscuro, que revelan algunos detalles nuevos de la secuela, así como declaraciones del... Leer el resto
El 02 septiembre 2013 por The Leff
NONE, NONE -
Musica: Going Underground - The Jam
THE JAM - GOING UNDERGROUND The Jam fue un grupo de rock inglés de new wave de finales de los años 1970 y principios de los años 1980. Fue uno de los grupos... Leer el resto
El 27 agosto 2013 por Light_19
NONE -
It Girl - LOUISE ROE

Buenos días de super domingo!!!!Hoy, como cada mes, en la sección It Girl conocemos a una de nuestras famosas con mas estilo del canal MTV en la tv: LOUISE... Leer el resto
El 25 agosto 2013 por Jadore88blog
-
Michael Rooker como Yondu en el rodaje de Los Guardianes de la Galaxia

Esta misma mañana, el equipo de producción de Los Guardianes de la Galaxia estuvo rodando una escena para la película en Surrey, de las cuales os dejamos a... Leer el resto
El 23 agosto 2013 por The Leff
NONE, NONE -
Flor de agosto......saintpaulia

La Saintpaulia o vioelta africana es toda una explosión de color sobre un manto aterciopelado. Una descripción algo sugerente, pero así es la planta del mes de... Leer el resto
El 06 agosto 2013 por Ayudaadecorar
NONE, NONE -
The “Old” Den, Londres

Existe un equipo en Inglaterra temido por la presión que ejerce su hinchada cuando juega de local. Sobre todo cuando jugaba en su anterior estadio. Leer el resto
El 05 agosto 2013 por El Domingo A Las Cinco Superbia In Proelio
-
¿Cómo afectará el caso Snowden el futuro de internet?

Las revelaciones que ha hecho hasta ahora el ex analista de la Agencia de Seguridad Nacional de Estados Unidos expuso el enorme y sofisticado aparato de... Leer el resto
El 05 agosto 2013 por Luiscastellanos
NONE -
Viaje temporal-8. Turista de la historia

Verano de 1980, sol, calor y una agradable brisa. Placenteros aires para las vacaciones de Pedro y Ernesto, que habían elegido el mes de agosto para disfrutar... Leer el resto
El 04 agosto 2013 por Xabelg
NONE, NONE -
Plutón, considerado como el "planeta enano"

El más lejano y menos conocido. Descubierto en 1930, perdió su condición de Planeta el 24 de Agosto de 2006, en la reunión celebrada en Praga. Leer el resto
El 26 julio 2013 por Monpalentina
NONE -
La realeza desnuda- LA FAMILIA REAL DE INGLATERRA

La realeza desnuda- LOS WINDSOR Durante los últimos 20 años ha trascendido una secuencia de escándalos, cada vez más sórdidos, en el seno... Leer el resto
El 17 julio 2013 por Clarena Roux
NONE -
Discos: Aural sculpture (The Stranglers, 1984)

¿Cómo evolucionar del punk original y seguir siendo una banda interesante, filosa, que fuera al frente con el mismo impulso original y sin resignar... Leer el resto
El 17 julio 2013 por Bruno
NONE, NONE -
[Spoilers] Guardianes de la Galaxia prevista para rodar en un campo del Reino...
![[Spoilers] Guardianes Galaxia prevista para rodar campo Reino Unido](https://m12.paperblog.com/i/197/1974576/spoilers-guardianes-galaxia-prevista-rodar-un-L-YKFF2Y-175x130.png)
Como Guardianes de la Galaxia se establece en gran medida en las profundidades del espacio, el rodaje se lleva a cabo principalmente en los estudios de cine... Leer el resto
El 07 julio 2013 por The Leff
NONE, NONE -
[Spoilers] Los Guardianes de la Galaxia prevista para rodar en un campo del Rein...
![[Spoilers] Guardianes Galaxia prevista para rodar campo Reino Unido](https://m12.paperblog.com/i/197/1975031/spoilers-guardianes-galaxia-prevista-rodar-un-L-9PfgcA-175x130.png)
Como Los Guardianes de la Galaxia se establece en gran medida en las profundidades del espacio, el rodaje se lleva a cabo principalmente en los estudios de... Leer el resto
El 07 julio 2013 por The Leff
NONE, NONE -
La Reina Isabel II tiene 2 primas confinadas en un manicomio?

Las primas ocultas de Isabel II En medio del mejor momento del reinado de Isabel II según expertos en realeza como Sarah Bradford (autora de la más reciente... Leer el resto
El 07 julio 2013 por Clarena Roux
-
ERIC CLAPTON y Doña Rosa

De una atractiva recopilación que hizo el Daily Mail con fotos de rockeros famosos de los '70 posando con familiares, hoy elijo ésta de Eric Clapton con su... Leer el resto
El 22 junio 2013 por Aldo
NONE -
El cine que no vimos/LII

Presentada en Edimburgo 2012, Locarno 2012 y Gérardmer 2013 –en este último festival ganó tanto el Premio Especial del Jurado como el Premio de la Crítica... Leer el resto
El 20 junio 2013 por Diezmartinez
NONE -
Las primas ocultas de la reina isabel ii

Primas ocultas de la reina: Fueron desterradas a un asilo en 1941 y las dejaron abandonadas Isabel Bowes-Lyon (Elizabeth Angela Marguerite Bowes-Lyon, Londres,... Leer el resto
El 19 junio 2013 por Clarena Roux
NONE, NONE -
Londres secreto: Caminando con el Támesis en Richmond
 El 25 mayo 2013 por Pablosolorzano
El 25 mayo 2013 por Pablosolorzano
NONE -
Las 10 casas más caras del mundo

La mayoría de nosotros nunca llegará a vivir en una casa de millones de euros. Sin embargo, hay un cierto grado de placer y emoción (además de envidia) que... Leer el resto
El 24 mayo 2013 por Duplex Pisos
NONE -
Marussia consigue nuevo patrocinante

Marussia ha firmado un nuevo patrocinio con Lets Race de cara al Gran Premio de Mónaco. El acuerdo hará que el centro de simulación de conducción que tiene la... Leer el resto
El 23 mayo 2013 por Rd
NONE, NONE -
Recordando la Música de los '60s (Parte 3)

Seguimos con los especiales que, a lo largo de todo este año 2013, rescataremos del olvido grandes discos conocidos o no, de la prolífica década de los sesenta. Leer el resto
El 21 mayo 2013 por Mumbo
NONE, NONE, NONE -
The police: outlandos d'amour

Outlandos d’Amour fue el álbum con el que The Police debutaron en esto de la música. Corría el año 1978 cuando fue grabado (Surrey Sound Studio en Leatherhead,... Leer el resto
El 16 mayo 2013 por Alberto CaÑas
NONE -
Niña de 12 años Salva a un Bosque

Olivia Peters es una niña de 12 años, que tras visitar el bosque Forest, notó una gran cantidad de árboles marcados con pintura naranja y unas... Leer el resto
El 13 mayo 2013 por Plantamer
NONE, NONE, NONE, NONE -
Falta de sueño: la pesadilla de los estudiantes

Sean Coughlan, BBC La falta de sueño ya es parte de nuestra cultura. La falta de sueño es un significativo factor oculto en el descenso del desempeño en... Leer el resto
El 10 mayo 2013 por Alfredomilano
NONE, NONE -
Hellen Allingham (1848-1926)

Niño en un camino fuera de una casa de campo de West Horsley Surrey Hellen Allingham fue una acuarelista e ilustradora de la época victoriana. Nació cerca de... Leer el resto
El 09 mayo 2013 por Andrula
NONE, NONE, NONE, NONE -
James Simon Wallis Hunt
(1947-1993), deportista británico, conocido especialmente por su dedicación a las carreras de motor. Campeón del Mundo de Fórmula 1 en 1976. Leer el resto
El 07 mayo 2013 por Alma2061
NONE, NONE -
Asesinados por el terrorismo que hoy gobierna Argentina
 El 30 abril 2013 por Clarena Roux
El 30 abril 2013 por Clarena Roux
NONE, NONE, NONE -
Quédate en mi vida de Ava Campbell

Quédate en mi vidaAva CampbellEditorial: Vergara / 3 Octubre 2012ISBN: 978-84-15420-22-4Género: Histórico Surrey, 1823. Anna Hurst llegó a Halston hace seis año... Leer el resto
El 17 abril 2013 por Hsusurradas
NONE, NONE -
Muchas mujeres pierden hasta cinco horas de sueño ala semana por los ronquidos d...
Los científicos analizaron el caso de 25 parejas. Su estudio, que se encuentra aún en su etapa inicial, forma parte de un proyecto más ambicioso que investiga l... Leer el resto
El 07 marzo 2013 por Andi
NONE, NONE -
Desvelado el papel que tendrá PS Plus en la PS4

NOTICIAS PLAYSTATION 4- Desvelado el papel que tendrá PS Plus en la PS4 El presidente de Sony Computer Entertainment Europe, Jim Ryan, y el vicepresidente... Leer el resto
El 04 marzo 2013 por Flopy75
NONE -
Numbers 2: El caos de Rachel Ward

Sinopsis:Adam ha heredado el don de su madre, Jem: cuando mira a alguien a los ojos puede ver la fecha en que la persona morirá. Para él, este poder también es... Leer el resto
El 03 marzo 2013 por Hanozos8
NONE, NONE -
Dormir poco de manera habitual puede tener un efecto dramático

James Gallagher, BBC El estudio revela que cientos de genes se alteran cuando se duerme poco habitualmente. Dormir poco de manera habitual puede tener un... Leer el resto
El 02 marzo 2013 por Alfredomilano
NONE -
Psicocuriosidad: la importancia del descanso

¿Sabías que recientes estudios han encontrado una relación directa entre dormir pocas horas y la existencia de alteraciones genéticas y hormonales? Leer el resto
El 27 febrero 2013 por Somospsico
NONE -
Bioarte creado con bacteria que se encuentra en los smartphones
El Bioarte es una de las nuevas corrientes del arte contemporáneo y según explican en Wikipedia, Tiene la particularidad de asumir a la biotecnología como un... Leer el resto
El 24 febrero 2013 por Geeksroom
NONE, NONE -
Laurence Olivier, actor, productor y director británico
Laurence Olivier (1907-1989), actor, productor y director británico unánimemente considerado como uno de los mejores actores del siglo XX. Olivier nació en... Leer el resto
El 08 febrero 2013 por Alma2061
-
Lo que nunca te contaran. cap.1

Nueva sección, que consiste en haceros llegas noticias, hayazgos, investigaciones.... que en ningún Telediario saldrán. Simplemente porque no quieren que sepamo... Leer el resto
El 16 enero 2013 por Jota_g2
-
Secretos cuánticos para proteger la información

Códigos secretos creados aplicando física cuántica fueron transmitidos por primera vez a distancias de kilómetros utilizando banda ancha común. El avance es... Leer el resto
El 08 diciembre 2012 por Barzana
NONE -
Entrevista a W.H. Auden: "nunca he tenido miedo de la oscuridad."

Wystan Hugh Auden (1907-1974), británico nacionalizado estadounidense, es uno de los mayores poetas del siglo pasado en lengua inglesa. Esta entrevista fue... Leer el resto
El 16 noviembre 2012 por Lilik
NONE -
Quédate en mi vida, Ava Campbell

Quédate en mi vida Editorial: Editorial Vergara PVP: 17.00 € ISBN: 978-84-15420-22-4 Páginas: 416 Surrey, 1823. Anna Hurst llegó a Halston hace seis... Leer el resto
El 12 noviembre 2012 por Rosaluque
NONE, NONE -
Encuentran esqueleto de paloma mensajera de la II Guerra Mundial con el mensaje...

Un hombre descubrió el esqueleto de una veterana paloma mensajera con un mensaje secreto de la Segunda Guerra Mundial unido a su pata mientras limpiaba su... Leer el resto
El 02 noviembre 2012 por Husmeandoporlared
NONE -
Cuento:" Jaqueline Ess: Su Volntada y Su Testamento" Tomado de Libros Sangriento...

JACQUELINE ESS:SU VOLUNTAD Y SU TESTAMENTO(Tomado de Libros Sangrientos II de Clive Barker) Jaqueline Ess: Su voluntad y su Testamento(Libros Sangientos II. Leer el resto
El 15 octubre 2012 por Fesb2011
NONE, NONE -
Gibbon Edward

1A ver, la situación es esta: Edward Gibbon decidió escribir sobre la decadencia y caída de la ciudad de Roma y su imperio el 15 de octubre de 1764, “sentado... Leer el resto
El 12 octubre 2012 por Peterpank
NONE, NONE, NONE, NONE -
Nuevo virus "Flame" el espia mas complejo de la historia

Descrito como "una de las amenazas más complejas jamás descubiertas", el programa malicioso podía desde grabar conversaciones privadas manipulando el micrófono... Leer el resto
El 08 octubre 2012 por Uncolgado
-
El maratonista más viejo del mundo: corrió 5 km a los 101 años

@DePuntin Récord mundial. Fauja Singh, de 101 años, participó de una carrera en Surrey, donde corrió 5 kilómetros en 40 minutos. Singh se dio el gusto de... Leer el resto
El 02 octubre 2012 por Pablo09
NONE, NONE -
Citas para cada día:

"No puedo volver al ayer, porque ya soy una persona diferente". Lewis Carroll , seudónimo por el que es conocido en la historia de la literatura Charles Lutwidg... Leer el resto
El 04 septiembre 2012 por Hada
NONE, NONE -
5 super alimentos para adelgazar

En una dieta, ¿se pueden comer batatas? ¿Y huevo? Sí: no sólo no engordan, sino que ayudan a quemar grasas. Acá te contamos por qué éstos y otros alimentos... Leer el resto
El 04 septiembre 2012 por Demoniatentacion
NONE -
THE DIRT TRACKS Estarán Presentando "The Madding Crowd" en Liverpool, Londres,...

La banda valenciana The Dirt Tracks continua con la gira presentación de su último lanzamiento "The Madding Crowd", que en los meses pasados llevo al grupo a... Leer el resto
El 28 agosto 2012 por Ivan
NONE, NONE -
Portada de Furia de Titanes 2 la pelicula
Esta es el Cobertor o portada de la pelicula Furia de Titanes 2 Wrath of the Titans (titulada en España Ira de Titanes y en Hispanoamérica Furia de Titanes 2... Leer el resto
El 27 agosto 2012 por Yoker1
-
La riqueza de la nación

Hace ya más de un año escribía sobre la "riqueza de las naciones" más allá del universo económico que todo lo domina. Reclamaba política y políticos, liderazgo ... Leer el resto
El 06 agosto 2012 por Jlmon
NONE, NONE -
El gobierno de internet
Es eficiente, popular, conveniente. Y ahi pasamos horas. Pero, ¿quien gobierna internet? Leer el resto
El 06 agosto 2012 por Xombra
NONE -
Beatles Memorabilia: La colección de Julian Lennon

Julian Lennon no nació en un buen momento. Sus padres, Cynthia y John, se habían casado precipitadamente el 23 de agosto de 1962, poco antes de que se lanzase e... Leer el resto
El 30 julio 2012 por Gww
NONE -
Camel – The Snow Goose (1975)

De entre las grandes obras conceptuales del rock de todos los tiempos, sin dudas “The Snow Goose” (1975) de la banda inglesa Camel se lleva gran parte de los... Leer el resto
El 27 junio 2012 por Peterpank
NONE, NONE -
STAN GETZ: People Time

STAN GETZ:People Time - Stan Getz: Saxo tenor.- Kenny Barron: Piano. CD 1:01. East Of The Sun (and west of the moon) 9:2902. Night And Day 8:1603. I'm Okay... Leer el resto
El 23 junio 2012 por Jazzc
NONE, NONE, NONE -
¡Arrepentíos pecadores!

Es muy habitual, en los parques de EEUU, que cualquier persona, se suba a una piedra, cajón o tarima y se dedique a exponer todo aquello que se le ocurra, en es... Leer el resto
El 20 junio 2012 por Marynela
NONE, NONE -
Tim Radford y sus 25 mandamientos para el periodista de a pie

Tim Radford ha sido Editor científico en el Guardian, y también Editor artístico y literario, y ha condensado su experiencia periodistica en un conjunto de... Leer el resto
El 03 mayo 2012 por Noblejas
NONE, NONE -
Versión Original: 'I will follow him'

Fue precisamente en abril, pero de 1963, que una quinceañera de Pennsylvania llamada Margaret Annemarie Battavio, llegaba al número uno de las listas de éxitos... Leer el resto
El 12 abril 2012 por Puchalt
NONE, NONE -
Olimpiadas de Londres 2012: eventos gratis

Te presentamos los eventos deportivos a los que puedes asistir durante los Juegos Olímpicos de Londres 2012 de forma totalmente gratuita. Ver... Leer el resto
El 03 abril 2012 por Pili_hb
NONE -
Un estudio revela que los espectadores asiduos al ballet clásico «adquieren»...
Los amantes del ballet clásico, aquellos espectadores que dominan la técnica de este arte en su versión teórica, pero que no lo practican, son capaces de... Leer el resto
El 25 marzo 2012 por Fat
NONE -
IBM anuncia las ciudades ganadoras del Smarter Cities Challenge 2012
Bienvenidos al Sitio Web www.informanet1.com Director General: Erasmo Martínez Cano… Comentarios y sugerencias: Editor: Erasmo Martínez / Javier Tlatoa (... Leer el resto
El 15 marzo 2012 por Erasmo
-
Heroínas, los poderes espirituales y las magas

La historia del arte occidental abunda en imágenes de mujeres seductoras, complacientes, sumisas, vencidas, esclavizadas. Pero también existen las figuras de... Leer el resto
El 31 enero 2012 por Peterpank
NONE, NONE, NONE -
Moral y felicidad

¿Dónde está el origen de que en los tiempos modernos se haya consumado el divorcio entre moral y el deseo felicidad? ¿Qué distingue la libertad de... Esto es l... Leer el resto
El 28 diciembre 2011 por Alvaromenendez
NONE -
El grado de satisfacción laboral afecta a la calidad del sueño

El grado de satisfacción laboral afecta a la calidad del sueño, según revela un estudio desarrollado por un grupo de investigadores británicos de la... Leer el resto
El 29 noviembre 2011 por Luiscastellanos
NONE, NONE -
Hawker Fury

La aeronave Hawker Fury («furia marina» en inglés) era un avión británico biplano avión de combate utilizado por la Royal Air Force en 1930. Originalmente... Leer el resto
El 17 noviembre 2011 por Alma2061
NONE, NONE -
Insólito: ¿Te imaginas caer en uno de estos baches gigantes? (Fotos)

Tweet ¿Alguna vez has caído en un odioso bache? Es probable que sí, pero es muy improbable que hayas caído en uno gigante, como le ocurrió a... Leer el resto
El 08 octubre 2011 por Braybaut
-
En todas partes hay problemas...

A medida que se dirigía a su oficina, la tierra se abrió y se tragó el coche. Afortunadamente el conductor, que no ha sido identificado, fue capaz de trepar... Leer el resto
El 08 octubre 2011 por Tavarez25
NONE -
Canciones con historia "Layla"

"El amor, si no es verdadero, no es más que un juguete de los sentidos, que dura tan poco como la juventud. El tiempo es perecedero, el amor no. El brasero de... Leer el resto
El 07 octubre 2011 por Puchalt
NONE, NONE -
Curiosidades en mis novelas: los medios de transporte, del s. XIX al XX

"Cada yarda de raíles del temido «gran caballo de hierro» constreñía el territorio de las tribus. Y no sólo los nativos tuvieron que doblegarse a su avance,... Leer el resto
El 03 octubre 2011 por Olivia
NONE -
Memorias de Joseph Grimaldi

Charles Dickens.Memorias de Joseph Grimaldi.Traducción, prólogo y notas de Eduardo Berti.Páginas de Espuma. Madrid, 2011.Fue el payaso más famoso de Inglaterra... Leer el resto
El 28 septiembre 2011 por Santosdominguez
NONE -
Fotografías, Maureen Bisilliat

Conocer la obra de la inglesa Maureen Bisilliat (Englefield Green, Surrey, 1931, Inglaterra) es enamorarse aún más por la fotografía. Hija de la pintora... Leer el resto
El 26 septiembre 2011 por Manigna
NONE, NONE -
La marca del demonio Sarah Rees Brennan

Editorial Versátil nos invita a leer esta aclamada novela juvenil fantástica. No sé si mejor o peor que otras pero de seguro que os encantará. Nick y Alan... Leer el resto
El 25 septiembre 2011 por Juneseventeen
NONE, NONE, NONE -
OBRA DEL MES: Alice vestida de vagabunda, fotografía de Lewis Carroll (1858).

Destacamos para el mes de septiembre esta fotografía, más que por su estética, técnica o relevancia, por la historia a la que va vinculada.La fotografía fue... Leer el resto
El 01 septiembre 2011 por Murice Restauracion Y Mas
NONE, NONE, NONE -
Esta Noche el Final de la 4ª Temporada de "Los Tudor" en LA-1

Llegó el fin de esta apasionante historia. La 1 ofrece este jueves los dos últimos episodios de la cuarta temporada de la serie protagonizada por el actor... Leer el resto
El 25 agosto 2011 por Cincotv
NONE, NONE -
La sucesión de Fibonacci en la naturaleza

http://www.neoteo.com/la-sucesion-de-fibonacci-en-la-naturaleza La sucesión de Fibonacci en la naturaleza Sábado... Leer el resto
El 22 agosto 2011 por Gonzonet
NONE -
David Nash, escultor

Hoy Joaquín Torres te recomienda al escultor británico David Nash. Nash nace en Esher, Surrey, en 1945, y es considerado como uno de los mayores impulsores del... Leer el resto
El 17 agosto 2011 por A-Cero Blog
NONE, NONE, NONE, NONE -
Una casa que "hace aguas" por todas partes

En realidad, y siendo exactos, esta casa no "hace aguas" sino que está sobre el agua. Se trata de la residencia de la escritora británica Josie Curran, una... Leer el resto
El 02 agosto 2011 por Etxekodeco
NONE, NONE -
DUELO POR UNA ANTIGUA NÉMESIS (9) [Dedicado a CAMINANTE]
![DUELO ANTIGUA NÉMESIS [Dedicado CAMINANTE]](https://m1.paperblog.com/i/60/602964/duelo-una-antigua-nemesis-9-dedicado-caminant-L-56ulDI-175x130.jpeg)
DUELO POR UNA ANTIGUA NÉMESIS(9)El Padre Brown miraba muy entretenido las caras de su amigo Flambeau y del Inspector Chase, los cuales no dejaban de observar y... Leer el resto
El 04 julio 2011 por Gkch
NONE, NONE -
View Suspended II – Un Formula 1 suspendido por alambres

Impresionante exposición de un monoplaza Mercedes-Benz Petronas de Formula 1 realizada por el artista holandés Paul Veroude consistente en la suspensión en... Leer el resto
El 28 junio 2011 por Jordiguzman
-
Sam Worthington

Samuel Henry J. «Sam» Worthington (Godalming, Surrey, Inglaterra, 2 de agosto de 1976) es un actor australiano. Worthington nació en Godalming, Surrey,... Leer el resto
El 26 junio 2011 por Ferency
NONE -
El mundo es un lugar oscuro: Michael Reeves. La posibilidad de otro horror...

Versión completa del estudio originalmente publicado en Pasadizo. com: “No nos engañemos: la muerte suele ser el camino más rápido para que hablen bien de ti... Leer el resto
El 22 junio 2011 por Esbilla
NONE -
Genesis auto suficiente

...Fue durante la vasta gira septentrional que Genesis emprendió a mediados de los ’70 para presentar su entonces primer álbum doble -la magnífica obra... Leer el resto
El 20 junio 2011 por Bitacorock
NONE -
Artículo: hablémos de libros

Surfeando y/o navegando por la red me encontré con una iniciativa interesante para hablar de los libros favoritos que, creo, tenemos todos, al menos quienes... Leer el resto
El 16 junio 2011 por ѕιℓνια Fιℓóℓogα
NONE -
'Furia de Titanes 2' busca carácter histórico

El director de la segunda parte de Furia de Titanes, el sudafricano Jonathan Liebesman, quiere que la nueva película tenga "el rigor histórico de Gladiator" y... Leer el resto
El 03 junio 2011 por Davicine
NONE -
La increible historia de jack churchill

Muchas historia increíbles hemos leído de la Segunda Guerra Mundial, pero muy pocas superan a la protagonizada por Jack Churchill: un extravagante capitán del... Leer el resto
El 30 mayo 2011 por Fehele
NONE, NONE -
Una anécdota personal con el maestro de traductores Peter Newmark

Curso 1993-1994. Me encontraba de lector de español en la Universidad de Gales, en Cardiff, mientras comenzaba la tesis sobre teoría y práctica de la... Leer el resto
El 25 mayo 2011 por Mora Fandos
NONE -
The Stranglers x 2: "No more heroes" (1977) & "Black and white" (1978)

"No more heroes" (United Artists, 1977)Lo primero que habría que decir de los Stranglers es que fueron grandes artesanos del sonido. Leer el resto
El 25 mayo 2011 por Bruno
NONE, NONE -
Luther jazz club : katie melua - live at the 02 arena (2009)

Que tal amigos ,de nuevo en esta noche de otoño tan particular en el club y completando una semana con maravillosas voces femeninas ,les traemos a continuacion... Leer el resto
El 29 abril 2011 por Luther
NONE, NONE -
Paul Weller – Studio 150

John William Weller nació en Surrey, Inglatera, en 1958. Paul Weller es uno de los grandes, y se puede decir que a lo largo de su carrera (lleva ya más de 30... Leer el resto
El 03 abril 2011 por Turner
NONE -
Hotel de 5 estrellas bajo tierra

Diseñado por el estudio de arquitectura ReardonSmith, este hotel de lujo con spa es un proyecto desarrollado para el Hersham Golf Club en Surrey, Londres. ¿Qu... Leer el resto
El 29 marzo 2011 por Oloman
-
VONDELPARK | Todo Un Misterio
No tengo ni idea de quien se esconde detrás del nombre artístico VONDELPARK, excepto que es de Surrey (UK) y que su discográfica Belga “R S” nos delata con un E... Leer el resto
El 15 marzo 2011 por Franzsound
NONE -
Airbone

Nuevo thriller de terror sobrenatural, actualmente se esta rodando en la localización de Surrey, Inglaterra. El film esta dirigido por Dominic Burns y... Leer el resto
El 01 marzo 2011 por Terrorweekend
NONE, NONE -
La percepción, cuando el Creador se arriesga o cuando lo real no es lo que...

En un condado al sureste de Inglaterra, en Surrey, se encuentra el famoso hipódromo de Epsom Downs. Este campo de carreras hípico se utilizaba ya desde casi el... Leer el resto
El 16 febrero 2011 por Artepoesia
NONE -
Manifiesto del escriba sencillo: 25 mandamientos para periodistas

Tim Radford lleva en el mundo del periodismo desde los 16 años y su máxima es escribir sencillo. El texto siguiente -ver el artículo original en The Guardian-... Leer el resto
El 27 enero 2011 por Jaimegarcia
NONE, NONE -
Cada vez dormimos menos y peor

Mujer, trabaja dentro y fuera de casa, 41 años, tres hijos. Desde que parió al primero, hace 10 años, le cuesta conciliar el sueño. Los problemas han ido a... Leer el resto
El 14 enero 2011 por Fat
NONE, NONE -
Pressing catch, ostias como panes.

Quien diga con veintitantos años que no conoce el pressing catch (presin cá para nosotros), en realidad miente o está dando una respuesta que me niego a creer.... Leer el resto
El 26 diciembre 2010 por Losplatoscomoojos
NONE -
la lógica de Lewis

Buena anécdota de la infancia de C. S. Lewis, clave para entender a este autor, y para interesarse por él, en mi opinión. La cuenta Carpenter en Los... Leer el resto
El 27 octubre 2010 por Jcercas
NONE -
Jerry E. Marsden, la muerte de un gigante

Jerry Marsden falleció el pasado 21 de septiembre de 2010, a la edad de 68 años, en su casa de Pasadena (California), rodeado de su familia. A pesar de su... Leer el resto
El 26 septiembre 2010 por Icmat
NONE -
Musica: Tears in Heaven - Eric Clapton
ERIC CLAPTON - TEARS IN HEAVENEric Patrick Clapton Shaw CBE (Ripley, Surrey, Inglaterra, 30 de marzo de 1945) es un guitarrista, cantante y compositor de rock... Leer el resto
El 01 septiembre 2010 por Light_19
NONE -
Nick Lowe x 2: Jesus of cool (1978) Labour of lust (1979)

Nick Lowe es uno de esos músicos y compositores algo subestimados por la historia "oficial" del rock. Luego de su paso por Brinsley Schwarz, banda pionera del... Leer el resto
El 20 julio 2010 por Bruno
NONE, NONE -
Oscar, el gato biónico

¿Quién dijo que los gatos negros traen mala suerte? Más bien todo lo contrario. Oscar fue víctima de un descuido, y gracias a su lastimoso episodio, hoy la... Leer el resto
El 26 junio 2010 por Marpa411
NONE -
Yo nací libre

Su nombre real es: Mathangi "Maya" Arulpragasam (o en tamil மாதங்கி 'மாயா' அருள்பிரகாசம்) (Londres, 17 de julio de 1977) es una rapera, grafitera y artista... Leer el resto
El 02 mayo 2010 por Xim
NONE